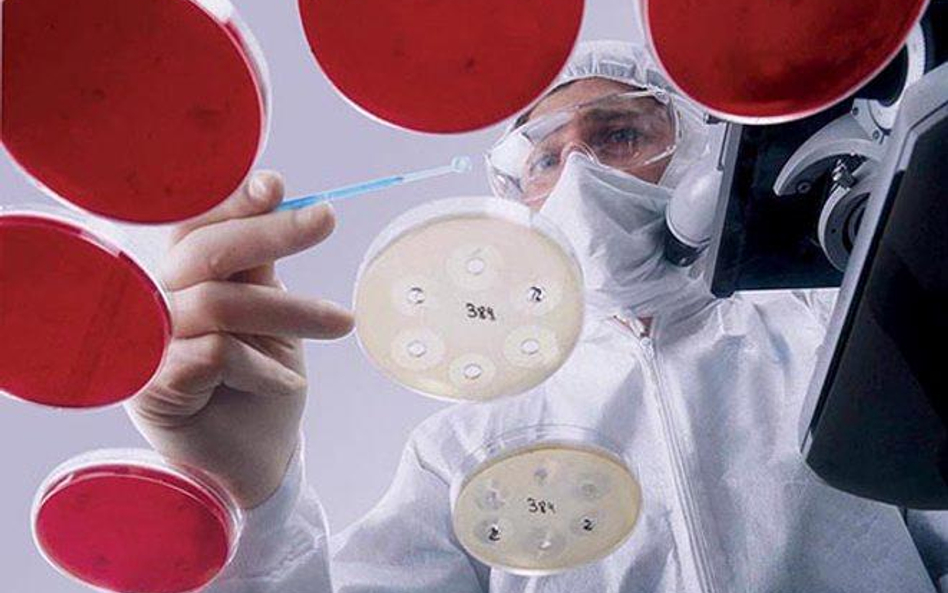
Laboratorium Teva Pharmaceutical Industries jedynej izraelskiej firmy wśród 500 największych na świe

-50% na pakiet subskrypcji RP.PL z NYT!
Skorzystaj z wiosennej promocji i ciesz się dwoma dostępami do najbardziej zaufanych źródeł informacji.
Promocja dotyczy rocznej subskrypcji pakietu RP.PL z The New York Times.
Kliknij i przejdź do szczegółów
Laboratorium Teva Pharmaceutical Industries jedynej izraelskiej firmy wśród 500 największych na świecie
Eleganckie audi sunie cicho zatłoczonymi ulicami Jerozolimy. Jedzie samo. Siedzący obok mnie kierowca od czasu do czasu zerka przed siebie. Jest zajęty tłumaczeniem zalet systemu prowadzącego auto.
Nie można w nim wybrać celu podróży, po czym spokojnie czytać gazetę. Za to samochód doskonale radzi sobie w korkach, wyręczając kierowcę.
Skorzystaj z wiosennej promocji i ciesz się dwoma dostępami do najbardziej zaufanych źródeł informacji.
Promocja dotyczy rocznej subskrypcji pakietu RP.PL z The New York Times.
Kliknij i przejdź do szczegółów